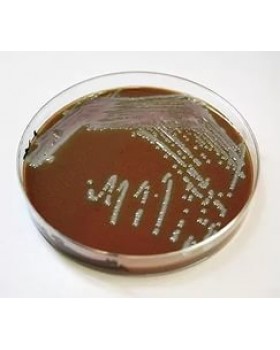
ПЕПТОН МАРТЕНА

СРЕДА РЕССЕЛЯ-ГРМ
(Питательная среда для
первичной идентификации энтеробактерий сухая)
Характеристика:
Среда Ресселя-ГРМ
предназначена для первичной идентификации энтеробактерий по признаку
ферментации лактозы и глюкозы.
Представляет собой
мелкодисперсный, гигроскопичный, светочувствительный порошок
светло-желтого цвета.
Состав:
Панкреатический
гидролизат рыбной муки, натрия хлорид, глюкоза, лактоза, бромтимоловый синий,
агар.
Приготовление:
Препарат в количестве,
необходимом для приготовления конкретной серии питательной среды, размешивают в
1 л дистиллированной воды, кипятят 2 мин до полного расплавления агара,
фильтруют через ватно-марлевый фильтр, разливают по 6-8 мл в стерильные пробирки
и стерилизуют автоклавированием в течение
20 мин при температуре 112 °С. Среду в пробирках скашивают, оставляя столбик
высотой 15-20 мм.
Готовая среда имеет
зеленый цвет.
рН 7,2±0,2
Стерильную среду можно
использовать в течение 3-х недель при условии ее хранения при температуре
2-8 C или в течение 3 суток при температуре хранения 18-25 °С (хранить пробирки
следует в защищенном от света месте).
Принцип действия:
Среда Ресселя-ГРМ
содержит углеводы, которые, разлагаясь с образованием кислоты, вызывают изменение
цвета индикатора бромтимолового синего из зеленого в желтый. При подщелачивании
индикатор дает синее окрашивание.
Проведение анализа:
Исследования образцов
проводятся по соответствующим Методическим указаниям и ГОСТам.
Исследуемую культуру
бактериологической петлей засевают в пробирку со средой уколом в столбик.
Инкубируют при температуре (37±1) °С в течение 18-20 ч.
Контроль качества:
Тест-штамм
Shigella flexneri I a 8516
Изменение цвета столбика
среды в желтый и посинение ее скошенной части
Salmonella paratyphi A-225
Изменение цвета столбика
среды в желтый с образование газа и посинением скошенной части среды
Alcaligenes faecalis 415
Изменение цвета всей
среды в синий или посинение ее скошенной части
Escherichia coli 055 К 59 № 339
Изменение цвета всей среды в желтый с образование газа в столбике
Срок годности: 2 года.
Вы смотрели
Интересные факты
История бенгальских огней
- 23.01.2025
Бенгальские огни – это яркие атрибуты праздника, неразрывно...
Подробнее..Почему, когда вливаешь воду в стакан, она оказывается на столе?
- 23.01.2025
Вы, вероятно, замечали, как при наливании жидкости...
Подробнее..Что такое аналемма?
- 22.01.2025
Возможно, вы обращали внимание на старинных глобусах на таинственную...
Подробнее..Можете добавлять сколько угодно вкладок (табов), с любой информацией : текст, фото, видео и т.д.